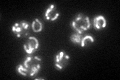
YOR065W

View description
Cytochrome c1, component of the mitochondrial respiratory chain; expression is regulated by the heme-activated, glucose-repressed Hap2p/3p/4p/5p CCAAT-binding complex
Localization:
Intensity:
Fold change:
Significance:
-
C’ GFP library in SD

mitochondria70 -
N' NOP1pr-GFP in SD

mitochondria114.582 -
N' TEF2pr-mCherry in SD

missing0 -
N' NATIVEpr-GFP in SD

mitochondria15.3409 -
N' TEF2pr-VC and Cyto-VN in SD

#N/A0 -
C’ GFP library in SD+DTT

mitochondria67.620.96No -
C’ GFP library in SD+H2O2

mitochondria63.980.91No -
C’ GFP library in Starvation Media
mitochondria97.661.39Yes -
C’ GFP library on the background of Pup2-DaMP

mitochondria -
C’ GFP library on the background of CCT mutant

mitochondria62.22560.888836No
